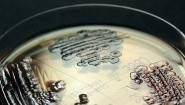
Multiresistente Enterobakterien - in einer Petrischale nachgewiesen. (Axel Hamprecht/IMMIH/dpa)

Sendung vom 24.04.2019
Sendung vom 23.04.2019
Renaturierung Die Emscher ist wieder ein Fluss
Sendung vom 18.04.2019
Wirkung intensiver Landwirtschaft„Ein Artenverlust von neun Prozent“
Müll von Morgen?Mikroplastik auf dem Acker
Sendung vom 17.04.2019
Kaffeetrinken ohne MüllHamburger Café setzt auf „Zero Waste“
SachsenProblemwölfe können geschossen werden
Backhaus in der PfalzBrot backen mitten im Dorf
Sendung vom 16.04.2019
LebensmittelverschwendungFranzösische Supermärkte sollen Strafen zahlen
Sendung vom 15.04.2019
Neonikotinoide„Eine Art Krieg gegen Insekten“
Sendung vom 11.04.2019
Trotz KlimaverträgenWeltbank investiert massiv in Kohle und Öl
Sendung vom 10.04.2019
Europäischer KlimaberichtWetterrekorde und eine düstere Prognose
Grüne DächerKlimaschutz mit Oregano und Rosmarin
Munition in der NordseeDas unsichtbare explosive Erbe
Sendung vom 09.04.2019
Chemieabfälle im WesterwaldDas giftige Erbe der Farbwerke Hoechst
Energiewende-Konferenz in BerlinElektrisch und erneuerbar
Sendung vom 08.04.2019
RusslandFragwürdige Entsorgung des Moskauer Mülls
Germania InsolvenzFlugreisende können Schaden online zurückfordern
Sendung vom 05.04.2019
Krebserkrankung eines KlägersNach Glyphosat-Urteil: Luxemburgs Regierung will Verbot
Luftverschmutzung in LondonHöhere City-Maut statt Fahrverbote
Sendung vom 04.04.2019
Bayern„Rettet die Bienen“: Vom Volksbegehren zum Gesetz
MobilitätVCD: Interessenskonflikt kocht mit den elektrischen Tretrollern hoch
Sendung vom 03.04.2019
Lebensmittelverschwendung Berliner Supermarkt verkauft gerettete Ware
Jubiläum von „Umwelt und Verbraucher“30 Jahre Umweltschutz – 30 Jahre gebrochene Versprechungen
Sendung vom 02.04.2019
PflanzenschutzmittelStreit um die Verlängerung von Zulassungen
EU-Vogelschutzrichtlinie wird 40„Zusätzliche Arten sind im Bestand bedroht“
Sendung vom 01.04.2019
Ökonom zur Energiepolitik„Wir müssen konventionelle Stromerzeugung teurer machen“
TierwohlEinheitliche Fleischkennzeichnung bei den Discountern
Sendung vom 29.03.2019
20 Jahre ÖkosteuerRentner profitieren, die Umwelt bisher kaum
ArtenvielfaltBürger pachten Blumenwiesen, um Bienen zu retten
Ökonom Edenhofer zu Klimaschutz und Elektromobilität„Benzin und Diesel stärker besteuern“
Nächste Sendung: 25.04.2019 11:35 Uhr
Umwelt und VerbraucherPodcast

Mit unseren Podcasts haben Sie die Sendung „Umwelt und Verbraucher“ immer dabei:
Verwandte Links
Marktplatz

Arbeitsplätze für SelbstständigeBürogemeinschaft, Co-Working oder Wohnzimmer

Behinderung und JobVielfalt als Teil der Lösung